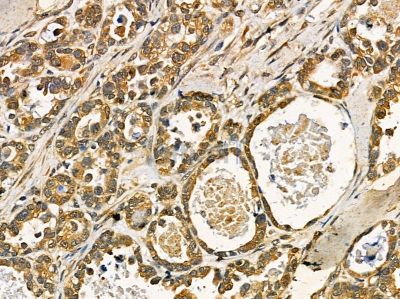
R-spondin1 Antibody - DF14450 at 1/100 staining human ovarian cancer by IHC-P.

R-spondin1 Antibody - #DF14450
Related Downloads
Protocols
Product Info
*The optimal dilutions should be determined by the end user. For optimal experimental results, antibody reuse is not recommended.
*Tips:
WB: For western blot detection of denatured protein samples. IHC: For immunohistochemical detection of paraffin sections (IHC-p) or frozen sections (IHC-f) of tissue samples. IF/ICC: For immunofluorescence detection of cell samples. ELISA(peptide): For ELISA detection of antigenic peptide.
Fold/Unfold
CRISTIN3; FLJ40906; hRspo1; R spondin homolog (Xenopus laevis); R spondin homolog; R spondin1; R-spondin-1; Roof plate specific spondin; Roof plate-specific spondin-1; RP11-566C13.1; RSPO; Rspo1; RSPO1_HUMAN;
Immunogens
A synthesized peptide derived from human R-spondin1.
Abundantly expressed in adrenal glands, ovary, testis, thyroid and trachea but not in bone marrow, spinal cord, stomach, leukocytes colon, small intestine, prostate, thymus and spleen.
- Q2MKA7 RSPO1_HUMAN:
- Protein BLAST With
- NCBI/
- ExPASy/
- Uniprot
MRLGLCVVALVLSWTHLTISSRGIKGKRQRRISAEGSQACAKGCELCSEVNGCLKCSPKLFILLERNDIRQVGVCLPSCPPGYFDARNPDMNKCIKCKIEHCEACFSHNFCTKCKEGLYLHKGRCYPACPEGSSAANGTMECSSPAQCEMSEWSPWGPCSKKQQLCGFRRGSEERTRRVLHAPVGDHAACSDTKETRRCTVRRVPCPEGQKRRKGGQGRRENANRNLARKESKEAGAGSRRRKGQQQQQQQGTVGPLTSAGPA
Research Backgrounds
Activator of the canonical Wnt signaling pathway by acting as a ligand for LGR4-6 receptors. Upon binding to LGR4-6 (LGR4, LGR5 or LGR6), LGR4-6 associate with phosphorylated LRP6 and frizzled receptors that are activated by extracellular Wnt receptors, triggering the canonical Wnt signaling pathway to increase expression of target genes. Also regulates the canonical Wnt/beta-catenin-dependent pathway and non-canonical Wnt signaling by acting as an inhibitor of ZNRF3, an important regulator of the Wnt signaling pathway. Acts as a ligand for frizzled FZD8 and LRP6. May negatively regulate the TGF-beta pathway. Has a essential roles in ovary determination. Regulates Wnt signaling by antagonizing DKK1/KREM1-mediated internalization of LRP6 through an interaction with KREM1.
Secreted. Nucleus.
Note: Seems to mainly localize to nucleoli.
Abundantly expressed in adrenal glands, ovary, testis, thyroid and trachea but not in bone marrow, spinal cord, stomach, leukocytes colon, small intestine, prostate, thymus and spleen.
The FU repeats are required for activation and stabilization of beta-catenin.
Belongs to the R-spondin family.
Restrictive clause
Affinity Biosciences tests all products strictly. Citations are provided as a resource for additional applications that have not been validated by Affinity Biosciences. Please choose the appropriate format for each application and consult Materials and Methods sections for additional details about the use of any product in these publications.
For Research Use Only.
Not for use in diagnostic or therapeutic procedures. Not for resale. Not for distribution without written consent. Affinity Biosciences will not be held responsible for patent infringement or other violations that may occur with the use of our products. Affinity Biosciences, Affinity Biosciences Logo and all other trademarks are the property of Affinity Biosciences LTD.